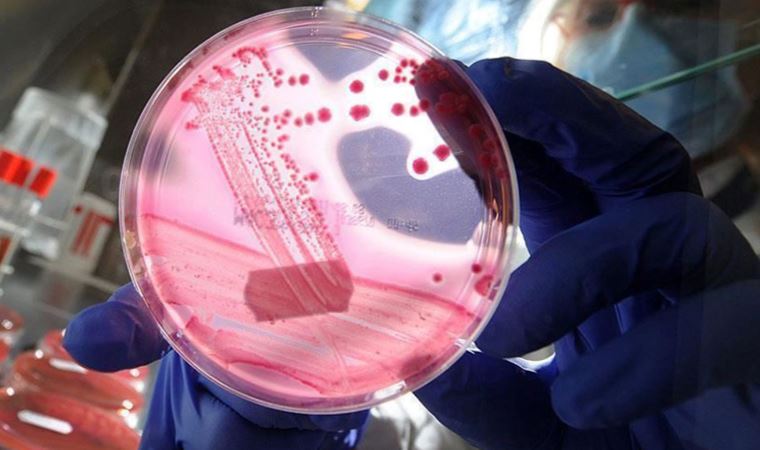
Kan kanserlerinde başarılı olan yöntem, meme kanserinde de umut olabilir

Kan kanserlerinde başarılı olan yöntem, meme kanserinde de umut olabilir
İstanbul’da 14-17 Eylül tarihleri arasında gerçekleştirilen 17’nci Dünya Aferez Kongresi, hematoloji alanının dünyadaki en önemli isimlerini bir …
İstanbul’da 14-17 Eylül tarihleri arasında gerçekleştirilen 17’nci Dünya Aferez Kongresi, hematoloji alanının dünyadaki en önemli isimlerini bir araya getirdi. Kongredeki konuşmacılardan biri de, vücut savunma hücrelerinin genetik mühendislikle programlanıp kanser hücrelerini yok etmesini sağlayan CAR-T hücre tedavisi için, Avrupa İlaç Ajansı EMA onayını almayı başaran ilk bilim insanı olan Prof. Dr. Julio Delgado oldu. DHA’ya açıklamalarda bulunan Prof. Dr. Delgado, kan kanserlerinde yüzde 90’a varan başarılı sonuçlar veren CAR-T hücre tedavilerinin, başta meme kanseri olmak üzere solid (kistik) tümörlerde de umut veren sonuçları olduğunu söyledi. CAR-T hücre tedavisinin, ilaç firmalarından bağımsız olarak, akademilerin kendi laboratuvarında üretilebildiğini kaydeden Prof. Dr. Delgado, programlanmış hücrelerin vücutta aylar hatta yıllarca kalabildiği için, kanser tedavisinde başarılı sonuçlar alınabildiğini kaydetti.

“KLASİK KANSER İLAÇLARI VÜCUTTA SADECE BİRKAÇ SAAT KALABİLİYOR”
Barcelona Üniversite Hastanesi Hematoloji Uzmanı Prof. Dr. Delgado, “CAR-T hücreleri, vücudun kendi beyaz kan hücrelerinin alınıp izole edildiği ve birtakım mühendisliklerle yeniden işlenip hastaya verildiği bir tedavidir. En önemli yönü vücutta aylarca, hatta yıllarca kalabilmesidir. Kanser tedavilerinde kullandığımız diğer hiçbir ilaç türü vücutta bu kadar uzun süre kalamıyor. Ancak saatlerden bahsedebiliyoruz diğer kanser ilaçları için. Bunlar çok uzun süre vücutta kalabiliyorlar ve insanın kendi hücrelerinden üretilen bir tedavi şekli. Bu yüzden kanserde çok kullanışlı ve potansiyeli olan bir yöntem. Vücutta kalıcılığı hastalığın tekrar etmemesi açısından da önemli. Bazı metotlarla bu kalıcılığı ölçebiliyoruz ve hücrelerin hala hastada bulunduğunu görünce seviniyoruz. Gerçekten de tedavi başarısı ve yanıtıyla, bu hücrelerin vücutta uzun süre kalıcılığı arasında çok önemli bir bağlantı var. Çünkü vücutta kaldıkça etkisi daha uzun sürüyor” dedi.
“HİÇBİR SEÇENEĞİ KALMAMIŞ HASTALARDA YÜZDE 90’A VARAN TEDAVİ YANITI”
Şu anda iki çeşit kan kanseri türünde CAR-T hücre tedavisinin FDA onaylı olduğunu vurgulayan Prof. Dr. Delgado, tedavi başarısıyla ilgili olarak da şunları söyledi: “İlk onaylandığı hastalık grubu, CD19 pozitif B hücreli hematolojik kanserler ki lösemiler, lenfomalar bunların arasına giriyor. İkinci onaylandığı hastalık da Multipl Miyeloma. BCMA dediğimiz geni hedefleyen tedaviler Multipl Miyeloma’da etkili. Özellikle Akut Lenfoblastik Lösemilerde (ALL) başka hiçbir seçeneği kalmamış hastalarda genel yanıt oranları yüzde 90’ları buluyor. Multipl Miyelom hastalarında ise yüzde 100’ü bulan genel yanıt oranları var. Yine bunlar da diğer kanser tedavilerinden sonuç alamamış hastalar. Tabii ki CAR-T hücre tedavisi almış bazı hastalarda sonradan nüksler de gelişebiliyor ama, başka seçeneği kalmayan hastalar açısından oldukça etkileyici yüksek yanıt oranları görülüyor.”
“ÇOCUKLARDAKİ BAŞARI ORANI DAHA YÜKSEK”
CAR-T hücre tedavilerinin, çocuklarda erişkinlere nazaran daha başarılı sonuçlar verdiğini de kaydeden Prof. Dr. Delgado, “Çocuklardaki T hücresi dediğimiz savunma hücreleri, erişkinlere nazaran daha iyi durumda. Bu nedenle çocuklardaki çalışmalarda daha başarılı sonuçlar elde edildi. Erişkinlerde de başarılı ama, çocuklar kadar yüksek değil. CAR-T hücreleri, kemik iliği ve kanda bulunan lenfositlerdeki T hücrelerinden üretiliyor. Çocuklardaki ve erişkinlerdeki lenfositler arasında fark var. Çocuklardaki lenfositler genellikle daha sağlıklı oluyor ve bu nedenle de CAR-T hücre tedavisindeki sonuçlar pediatride (örneğin ALL’de) erişkinlerdekinden daha iyi sonuçlar veriyor” diye konuştu.
“DİĞER KANSERLERDE METASTAZI ÖNLEME VE TEDAVİSİNDE BAŞARILI OLUNABİLİR”
CAR-T hücrelerinin hematolojik kanserler dışında pek çok merkezde solid kanserler (yani kistik tümörler) için de denendiğine işaret eden Prof. Dr. Delgado, özellikle meme kanseri açısından başarılı sonuçlar elde edildiğini söyledi. Prof. Dr. Delgado, şu bilgileri verdi: “Meme kanserlerinde bulunan HER2 dediğimiz molekülün pozitifliğini hedefleyen hücreler üzerinde çalışılıyor. Pekçok sebepten dolayı solid tümörler hematoloji kanserlere göre daha zor. Ama ben yine de iyimserim ve önümüzdeki 5-10 yıl içinde muhtemelen solid tümörlerle ilgili de CAR-T hücre tedavilerinin metastazların önlenmesi ya da tedavisi açısından işe yaradığını gösteren çalışmalar sonuç verecek ve bu tedavi şekli diğer kanser türleri için de umut olacak.”
“KEMİK İLİĞİ NAKLİNİN TEDAVİDEKİ KONUMUNU DEĞİŞTİRDİ”
Kemik iliği naklinin kan kanserleri açısından hala önemli bir seçenek olduğunu da vurgulayan Prof. Dr. Delgado, CAR-T hücre tedavilerinin kemik iliği naklinin yerini henüz alamayacağını, ama ‘konumunu’ değiştirdiğini söyledi. Prof. Dr. Delgado, “ALL’de kemik iliği nakli hala önemli bir seçenek. Bizim merkezimizde de ilik nakli yaptığımız çok hastamız var. Ama ilik naklinin çalışmadığı hastalar oluyor. Bu hastalar için CAR-T hücre tedavisi umut oluyor. Hem kemik iliği naklinden sonra nükseden hastalar için elimizde yeni bir silah daha oluyor hem de artık günümüz pratiğinde çok seçeneği kalmamış hastalarda, önce CAR-T hücre tedavisini kullanıp eğer bir yanıt elde edilemezse ya da nüks olursa o zaman ilik naklini konumlandırmak daha mantıklı oluyor. Yani bu tedaviler kan kanserlerinde ilik naklinin konumunu da değiştirecek” dedi.
“FİRMALARDAN BAĞIMSIZ, MERKEZLER KENDİLERİ ÜRETEBİLİR”
CAR-T hücre tedavileri, kişiye özel ve genetik mühendislikle çalışıldığı için şu anda en büyük açmazı, çok pahalı olması. Ancak Prof. Dr. Delgado, zamanla bunun da değişeceğine inandığını söyledi. CAR-T hücre tedavilerini üretmek için bilim dünyasının ilaç firmalarına bağımlı olmadığını kaydetti ve sözlerini şöyle noktaladı: “Bu tedaviler çok pahalı. Bu problemi sadece fakir ülkeler değil, zengin ülkeler de yaşıyor. Ama bu maliyetleri azaltmanın bir yolu var. Eğer akademik merkezler kendi CAR-T hücrelerini üretebilirlerse ki, CAR-T hücre tedavisi doğası gereği buna müsait, o zaman fiyatlar da düşecektir. Ama kendi merkezinizde üretseniz bile bir viral gen transferi yapmanız gerekiyor. İleride bazı yeni metotlar çıkıp bu viral transferleri ucuzlatabilir. İlaç firmalarından bağımsız bir şekilde kendi merkezinizde üretim yapabiliyorsunuz. Yeni teknolojilerle belki maliyet de daha düşeceği için, bu tedavilerin bir süre sonra daha düşük fiyatlara hastalara ulaştırılabileceğini düşünüyorum.”
KAYNAK: Cumhuriyet